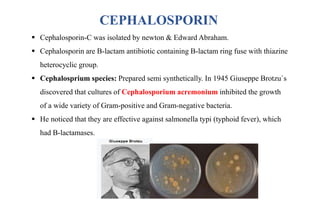
CEPHALOSPORIN
 Cephalosporin-C was isolated by newton & Edward Abraham.
 Cephalosporin are B-lactam antibiotic containing B-lactam ring fuse with thiazine
heterocyclic group.
 Cephalosprium species: Prepared semi synthetically. In 1945 Giuseppe Brotzu`s
discovered that cultures of Cephalosporium acremonium inhibited the growth
of a wide variety of Gram-positive and Gram-negative bacteria.
 He noticed that they are effective against salmonella typi (typhoid fever), which
had B-lactamases.

Cephalosporins are β-lactam antibiotics containing a β-lactam ring fused to a thiazine ring. They were first isolated from the fungus Cephalosporium acremonium. Cephalosporins work by inhibiting bacterial cell wall synthesis through binding to transpeptidase enzymes. They are classified into generations based on their spectrum of activity, with later generations more active against gram-negative bacteria. Common side effects include diarrhea, hypersensitivity reactions, and nephrotoxicity.